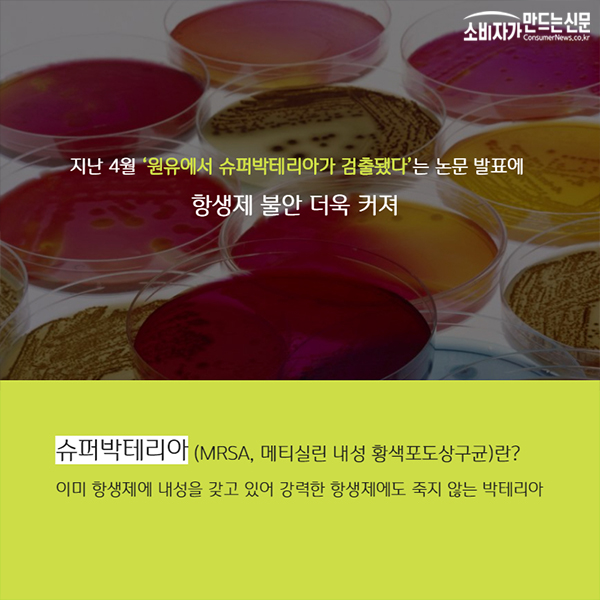
3.jpg

#1 내가 마신 우유가 항생제와 성장호르몬 범벅이라고?
“NO! 오해십니다~”
#2 “사람도 엄마가 먹은 음식이 모유를 통해 아이에게 가는데 소도 똑같지 않겠냐는 걱정이 앞서 우유 안먹어요” -경기도 가평군에 사는 A씨.
젖소가 먹는 항생제나 성장호르몬이 우유를 통해 사람에게 전달된다는 괴담 만연.
#3 지난 4월 ‘원유에서 슈퍼박테리아가 검출됐다’는 논문 발표에 항생제 불안 더욱 커져
* 슈퍼박테리아(MRSA, 메티실린 내성 황색포도상구균)란?
- 이미 항생제에 내성을 갖고 있어 강력한 항생제에도 죽지 않는 박테리아.
#4 하지만 우유에서 ‘항생제’ 검출 확률은 제로(0%)!
일반 젖소에는 항생제 투여안해.
질병이 있는 젖소에서 착유된 우유는 모두 폐기.
페니실린G 0.004ppm, 옥시테트라싸이클린 0.1ppm 미만으로 엄격한 잔류허용 기준.
기준을 통과하지 못하면 전량 폐기.
원유는 가공과정에서 살균 처리.
#5 매일유업, 남양유업 서울우유 등 유업체들도 '우유 규격 검사' 통해 항생제 포함 여부, 체세포 수 확인. 따라서 시판되는 우유는 모두 항생제 프리!
#6 그럼 성장호르몬은?
우유자조금관리위원회 “국내 젖소는 28kg의 우유를 생산하는 고능력 젖소라 인공호르몬제투여 필요 없다. 원유가 남아도는데 따로 비용들여 성장호르몬을 투여할 이유도 없다”
#7 항생제, 성장호르몬 등 불안 덜어내고 우유 즐기셔도 되겠죠~!!



